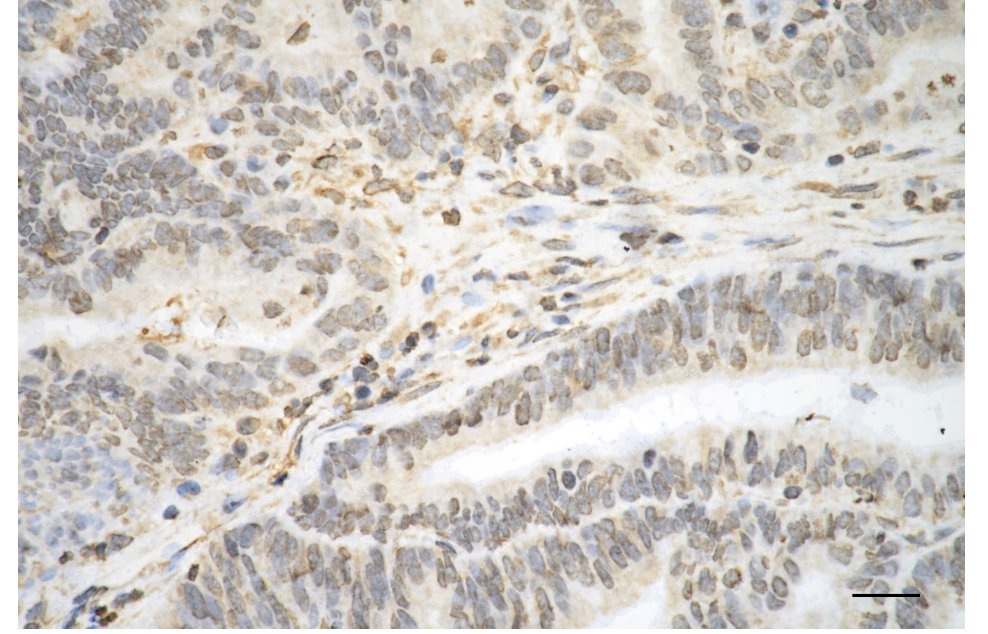

-
中文名稱:VIM Monoclonal Antibody
-
貨號:CSB-MA943929
-
規格:¥1320
-
圖片:
-
Flow cytometric analysis of vimentin expression in C2C12 cells using vimentin antibody. Green, isotype control; red, vimentin.
-
Immunocytochemical staining of Hela cells with vimentin antibody. Nuclei were stained blue with DAPI; Vimentin was stained magenta with Alexa Fluor? 647. Images were taken using Leica stellaris 5. Protein abundance based on laser Intensity and smart gain: High. Scale bar: 20 μm.
-
Immunohistochemistry was performed on paraffin-embedded human endometrial carcinoma using vimentin antibody. Antigen retrieval was done in sodium citrate buffer (pH 6.0). DAB was used for detection, with hematoxylin counterstaining. Images were acquired using a Nikon Ci-L Plus microscope (40× objective). Scale bar: 25 μm.
-
Western blotting analysis using Vimentin antibody. Total cell lysates (30 μg) from various cell lines were loaded and separated by SDS-PAGE. The blot was incubated with Vimentin antibody and HRP-conjugated goat anti-mouse secondary antibody respectively.
-
-
其他:
產品詳情
-
產品名稱:Mouse anti-Homo sapiens (Human) VIM Monoclonal antibody
-
Uniprot No.:
-
基因名:
-
別名:VIM; Vimentin; Epididymis Secretory Sperm Binding Protein
-
宿主:Mouse
-
反應種屬:Human, Mouse, Rat
-
免疫原:Recombinant Human VIM protein
-
免疫原種屬:Homo sapiens (Human)
-
標記方式:Non-conjugated
-
克隆類型:Monoclonal
-
抗體亞型:Mouse IgM kappa
-
純化方式:Affinity-chromatography
-
克隆號:13F10
-
濃度:It differs from different batches. Please contact us to confirm it.
-
保存緩沖液:PBS (pH 7.4) containing 50% glycerol, and 0.02% sodium azide.
-
產品提供形式:Liquid
-
應用范圍:ELISA, WB, FC, ICC, IHC
-
推薦稀釋比:
Application Recommended Dilution WB 1:2500-1:5000 FC 1:200-1:2000 ICC 1:100-1:1000 IHC 1:50-1:100 -
Protocols:
-
儲存條件:Upon receipt, store at -20°C or -80°C. Avoid repeated freeze.
-
貨期:Basically, we can dispatch the products out in 1-3 working days after receiving your orders. Delivery time maybe differs from different purchasing way or location, please kindly consult your local distributors for specific delivery time.
-
用途:For Research Use Only. Not for use in diagnostic or therapeutic procedures.
相關產品
靶點詳情
-
功能:Vimentins are class-III intermediate filaments found in various non-epithelial cells, especially mesenchymal cells. Vimentin is attached to the nucleus, endoplasmic reticulum, and mitochondria, either laterally or terminally.; Involved with LARP6 in the stabilization of type I collagen mRNAs for CO1A1 and CO1A2.
-
基因功能參考文獻:
- This study measured the effects of vimentin expression on the mechano-elastic and migratory properties of the highly invasive breast carcinoma cell line MDA231. It demonstrated that vimentin stiffens cells and enhances cell migration in dense cultures, but exerts little or no effect on the migration of sparsely plated cells. PMID: 29022351
- Positive vimentin expression could serve as a poor prognostic marker in gastric cancer[review, meta-analysis] PMID: 30078472
- High vimentin expression is associated with pancreatic cancer. PMID: 29956814
- the HDAC inhibitors augmented both Ecadherin and vimentin expression and their effects varied in different cholangiocarcinoma cell lines. Therefore, the clinical use of HDAC inhibitors in biliary cancer should be considered cautiously PMID: 29767267
- miR-373 suppresses gastric cancer metastasis by downregulating vimentin. PMID: 29257346
- Vimentin role in the M2BP inhibition of the HIV-1 virion production.M2BP mediates the interaction between HIV-1 Gag and Vimentin. PMID: 27604950
- Desmin, Glial Fibrillary Acidic Protein, Vimentin, and Peripherin are type III intermediate filaments that have roles in health and disease [review] PMID: 29196434
- Silencing of Vimentin in CNE2 cells leads to a decrease of microvessel density and VEGF, CD31, MMP2, and MMP9 expressions in pulmonary metastatic tumors. PMID: 28744809
- Carcinoid-like/labyrinthine pattern of cell arrangement in vimentin/cytokeratin 20 expressing sebaceous neoplasms may represent a morphological phenotype of sebaceous mantles. PMID: 28027080
- Cell surface vimentin mediates DENV-2 infection of vascular endothelial cells. PMID: 27910934
- HIF-1alpha expression was upregulated in the vasculogenic mimicry-positive CRC cell line HCT-116 and thereby affected the expression of the EMT-related markers Claudin-4, E-cadherin (E-cd) and Vimentin(VIM). PMID: 27869227
- our results demonstrated that vimentin in human GC tissues and cell lines was upregulated due to its de-ubiquitination after interactions with USP14 and miR-320a, which could promote the aggressiveness of GC cells. PMID: 27448976
- Knocking down long pentraxin-3 (PTX3) or vimentin repressed oleate-induced head and neck squamous cell carcinomas (HNSCCs) invasion. PMID: 28489600
- stromal vimentin expression is a promising indicator for survival prediction and adjuvant chemotherapy response in patients with stage II colorectal cancer with high-risk factors for recurrence. PMID: 28611349
- Vimentin and its interaction with Shigella flexneri IpaC are dispensable for effector translocation pore formation, but are required for stable docking of Shigella flexneri to cells; moreover, stable docking triggers effector secretion. PMID: 27572444
- the elongation reaction of vimentin in solution and in situ by time-resolved static and dynamic light scattering, is reported. PMID: 27655889
- Vimentin induced by exosomes is necessary for lung cancer to induce mesenchymal transition (EMT) in recipient bronchial epithelial cells (HBECs). PMID: 27363026
- our results demonstrate that vimentin silencing in ovarian cancer cells upregulates proteins of the exocytotic process to decrease cellular cisplatin accumulation PMID: 27322682
- The combined biomarkers E-cadherin, membranous epidermal growth factor receptor (EGFR) and vimentin show a stronger prognostic value for and disease-free survival than any of the single biomarkers. PMID: 27172790
- AHR protein-vimentin protein complex is formed in the cytoplasm resulting in proteasome degradation of vimentin. PMID: 27752740
- TRIM56 is the ubiquitin ligase that is degrading vimentin in ovarian cancer cells, regulation cell migration and neoplasm invasiveness. PMID: 28771721
- TIS21 attenuated Doxorubicin-induced cancer cell senescence by inhibiting linear actin nucleation via Nox4-ROS-ABI2-DRF signal cascade PMID: 27932314
- this study indicates that OPN can induce epithelial-mesenchymal transition of hepatocellular carcinoma cells through increasing vimentin stability PMID: 26824421
- The findings support a mechanism in which miR-375 suppresses RUNX1 levels, resulting in reduced vimentin and L-plastin expression. Knockdown of RUNX1, L-plastin, and vimentin resulted in significant reductions in cell invasion in vitro, indicating the functional significance of miR-375 regulation of specific proteins involved in head and neck squamous cell carcinoma (HNSCC) invasion. PMID: 28499703
- Vimentin expression was an adverse prognostic factor for DSS in TSCC patients, even after the adjustment for cell differentiation, pathological stage, and expression levels of Snail, Twist, E-cadherin, and N-cadherin. Snail, E-cadherin, N-cadherin, and Vimentin were associated with tumorigenesis and pathological outcomes PMID: 28570699
- circulating anti-vimentin IgG autoantibody levels are much greater in idiopathic pulmonary fibrosis subjects than in normal controls PMID: 28754682
- RhoA/ROCK and Raf-1/CK2 pathway are responsible for TNF-alpha-mediated endothelial cytotoxicity via regulation of the vimentin cytoskeleton. PMID: 28743511
- It was concluded that islet cell expression of vimentin indicates a degree of plasticity and dedifferentiation with potential loss of cellular identity in diabetes. PMID: 28348116
- findings have identified a role for members of these signaling pathways in the regulation of EGF-induced vimentin expression in the MDA-MB-468 breast cancer cell line PMID: 27163529
- changes in methylation levels in cfDNA associated with hepatocellular carcinoma and could represent useful plasma-based biomarker PMID: 28333958
- vimentin regulates the differentiation switch via modulation of K5/K14 expression. Moreover, because there was a significant correlation between high vimentin-K14 expression and recurrence/poor survival in oral cancer patients, vimentin-K14 together may prove to be the novel markers for the prognostication of human oral cancer. PMID: 28225793
- Data indicate that ellagic aicd (EA) down-regulates the expression of COX-2, NF-kappa B, vimentin and up-regulates the expression of E-cadherin in in pancreatic carcinom PANC-1 cells. PMID: 28135203
- Bevacizumab treatment was also associated with structural protein abnormalities, with decreased GFAP and vimentin content and upregulated GFAP and vimentin mRNA expression. PMID: 28419863
- Decreasing cell surface vimentin by small interfering RNA (siRNA) knockdown in HeLa and NIKS cells significantly increased human papillomavirus 16 infectious internalization, while overexpression of vimentin had the opposite effect identifying vimentin as a viral restriction factor. PMID: 28566373
- From these data, we suggest that filamentous vimentin underneath the plasma membrane is involved in increasing integrin adhesiveness, and thus regulation of the vimentin-integrin interaction might control cell adhesion PMID: 27044755
- depletion induces phosphorylation of the microtubule-associated GEF-H1 on Ser886, and thereby promotes RhoA activity and actin stress fiber assembly. PMID: 28096473
- Data show that the filament elongation of both desmin and keratin K8/K18 proceeds very similar to that of vimentin. PMID: 27304995
- Coexistence of vimentin-positive and Axl-high expression is a poor prognostic factor for primary breast cancer. Vimentin and Axl expression might contribute to the aggressive phenotype in breast cancer. PMID: 27506606
- our findings suggest that the HIF-1alpha-HDAC1 complex transcriptionally inhibits miR-548an expression during hypoxia, resulting in the upregulation of vimentin that facilitates the pancreatic tumorigenesis. PMID: 27353169
- Rab7a depletion decreases the amount of active Rac1 but not its abundance and reduces the number of cells with vimentin filaments facing the wound, indicating that Rab7a has a role in the orientation of vimentin filaments during migration PMID: 27888097
- Over-expression of TNC, SMA, and vimentin were significantly correlated with the lower overall survival in prostate cancer patients. PMID: 28341124
- Results show that VIM mRNA is regulated in melanoma by UNR protein. PMID: 27908735
- These findings suggest that Plk1 regulates smooth muscle contraction by modulating vimentin phosphorylation at Ser-56. PMID: 27662907
- Structural Dynamics of the Vimentin Coiled-coil Contact Regions Involved in Filament Assembly as Revealed by Hydrogen-Deuterium Exchange.( PMID: 27694444
- These findings are the first to demonstrate that vimentin is critical for influenza viral infection as it facilitates endosomal trafficking and acidification, and mediates viral genome penetration into the cytoplasm to propagate the infection. PMID: 27423069
- RAP1 promotes colorectal cell migration through the regulation of Vimentin and RAP1 may act as a potential target for the diagnosis and therapy of CRC. PMID: 28381157
- High vimentin expression is associated with Non Small-cell Lung Cancer. PMID: 28373440
- data demonstrates that keratinocyte migration requires the interaction between vimentin and keratins at the -YRKLLEGEE- sequence at the helical 2B domain of vimentin PMID: 27072292
- High vimentin expression is associated with malignant pleural mesothelioma. PMID: 27646775
- Increased TET1 induced re-expression of vimentin through active DNA demethylation, and cause partial epithelial-to-mesenchymal (EMT) in A2780 cells. PMID: 28150354
顯示更多
收起更多
-
相關疾病:Cataract 30, multiple types (CTRCT30)
-
亞細胞定位:Cytoplasm. Cytoplasm, cytoskeleton. Nucleus matrix. Cell membrane.
-
蛋白家族:Intermediate filament family
-
組織特異性:Highly expressed in fibroblasts, some expression in T- and B-lymphocytes, and little or no expression in Burkitt's lymphoma cell lines. Expressed in many hormone-independent mammary carcinoma cell lines.
-
數據庫鏈接:
Most popular with customers
-
YWHAB Recombinant Monoclonal Antibody
Applications: ELISA, WB, IHC, IF, FC
Species Reactivity: Human, Mouse, Rat
-
Phospho-YAP1 (S127) Recombinant Monoclonal Antibody
Applications: ELISA, WB, IHC
Species Reactivity: Human
-
-
-
-
-
-